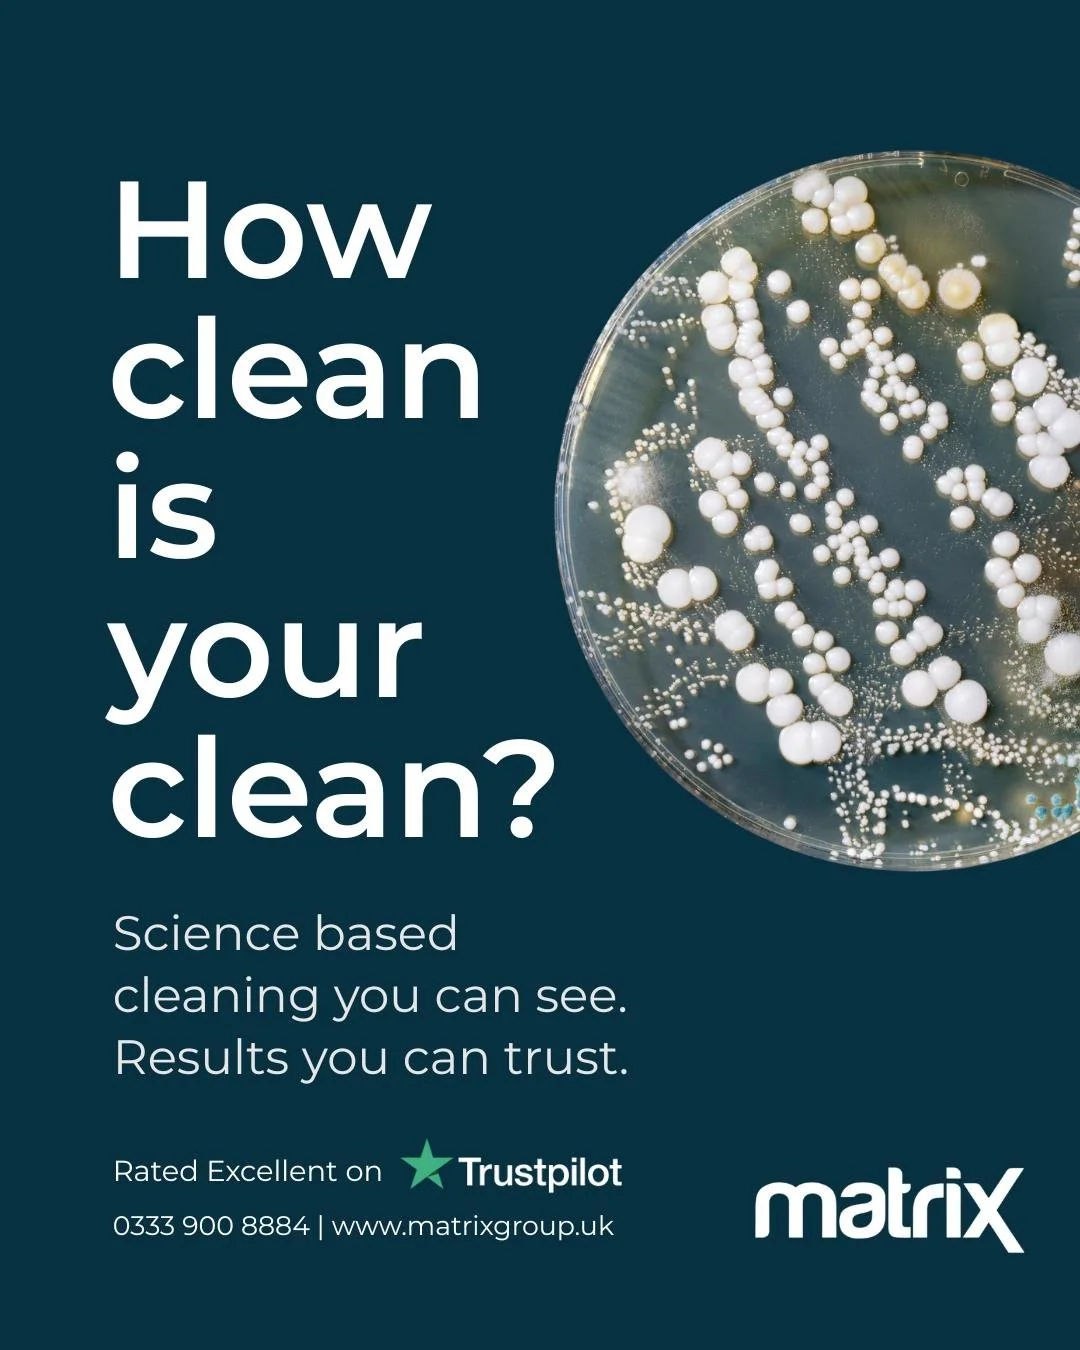
Clean shouldn&rsquo;t be a matter of opinion or a visual guess...

Call Us 24/7 on 0333 900 884 or Contact Us Online

Get in touch

Email Us
Phone: 0333 900 8884

Call Us
Matrix Group
9 Old Field Road, BOCAM Park, Pencoed. CF35 5LJ

Head Office
Send us a message
Follow our social media